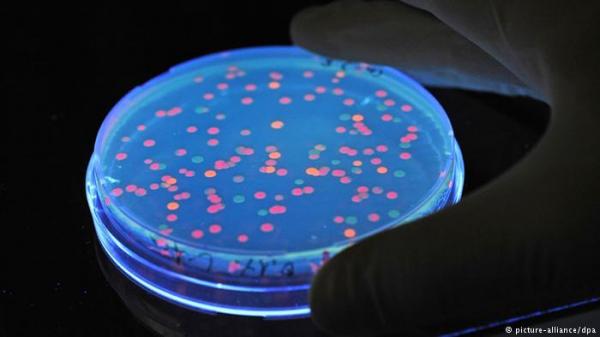
الحكومة المصرية توقف وجبات مدرسية بعد حالات تسمم غذائي

دويتشه فيله
قالت وزارة الصحة المصرية ووكالة الأنباء الرسمية ومصادر طبية إن أعراض تسمم غذائي ظهرت على 395 تلميذاً في مدارس بالقاهرة ومحافظات أخرى أمس الأربعاء وإن سيارات الإسعاف نقلتهم إلى المستشفيات لعلاجهم.
وأعلنت الحكومة وقف توزيع الوجبات المدرسية على مستوى الجمهورية لحين إجراء تحقيقات. هذا وكانت أعراض مماثلة قد ظهرت على نحو مائة تلميذ في مدرستين بمحافظة المنوفية في دلتا النيل بعد تناولهم الوجبة المدرسية التي تقدم مجاناً. وظهرت الأعراض قبل أسبوع على 3356 تلميذاً في عشر مدارس بمحافظة سوهاج جنوب البلاد.
وقالت وزارة الصحة في بيان إن 211 تلميذاً في محافظة السويس و98 تلميذاً في محافظة أسوان وثلاث تلميذات في مدرسة بوسط القاهرة ظهرت عليهم الأعراض يوم الأربعاء. كما أوردت وكالة أنباء الشرق الأوسط أن 48 تلميذاً ظهرت عليهم الأعراض في مدرسة بمحافظة بني سويف جنوبي القاهرة، ونقلت عن مدير مستشفى قوله إن هناك مصابين يعانون من إسهال وقيء ومغص لكن حالتهم مستقرة.
أما الشرطة في المحافظة فقد قالت في بيان إن السلطات ألقت القبض على المورد الرئيسي للبسكويت الذي تناوله التلاميذ. وأوضح لطفي عبد السميع، وكيل وزارة الصحة في السويس، أن حالة الطوارئ قد أعلنت في المستشفى العام بالمحافظة، مضيفاً أن عمليات لغسل المعدة أجريت لتلاميذ. من جانبه، أكد وزير التربية والتعليم، طارق شوقي، للتلفزيون المصري، أن الوزارة اتخذت "قراراً بوقف الوجبات المدرسية حفاظاً على صحة التلاميذ".